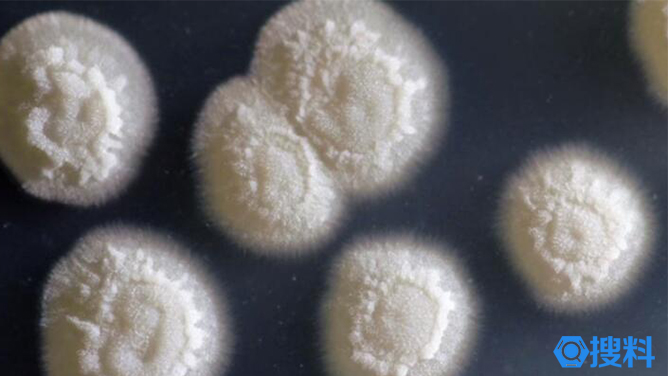

奇葩资料:把宇航员的尿液变成塑料
已有人阅读此文 - -

帝斯曼推出新型PA6材料,用于大型储氢压力容器的内衬
- 阅389
扫描上图二维码,可以免费下载 搜料 APP 帝斯曼工程材料有限公司有限公司推出了FLX40-HP和FLX-LP两个新产品品牌,用作IV型储氢压力容器的内衬材料。通过将这些新材料添加到Akulon Fuel...
新智能皮肤!喷涂智能皮肤用AI理解手部任务
- 阅191
扫描上图二维码,可以免费下载 搜料 APP 美国斯坦福大学开发的一种新智能皮肤可能表明,有一天,人们可以在隐形键盘上打字,只通过触摸识别物体,或者允许用户在沉浸式环境中通...
在美国实现本土制造,NILIT公司生产SENSIL® EcoCare高性能再生尼龙
- 阅204
扫描上图二维码,可以免费下载 搜料 APP 世界领先的服装用尼龙制造商NILIT推出了新版本的SENSIL EcoCare再生尼龙66,该产品在弗吉尼亚州马丁斯维尔的北美工厂生产,完全由美国材料制成...
研究人员将植物废料转化为生物基多元醇,用于聚氨酯保温材料
- 阅257
扫描上图二维码,可以免费下载 搜料 APP 土耳其的一组研究人员在埃斯基希尔理工大学实验室通过甜菜浆、番茄、胡椒、薰衣草、百里香浆、豌豆、红芸豆荚和其他植物材料的液化生产...
99.99%抑菌!妙抗保推出水性涂料新一代抗菌剂LapisShield
- 阅196
扫描上图二维码,可以免费下载 搜料 APP 近日,妙抗宝国际(Microban International)发布新型抗菌助剂产品LapisShield。该产品采用不含重金属的广谱抗菌技术,通过添加到水基涂料配方体系...
可替代金属!道默化学开发出基于PA6的新产品
- 阅318
扫描上图二维码,可以免费下载 搜料 APP 最近,道默化学(DOMO)宣布了其在技术气体市场的最新成功案例。DOMAMID 6IK4UV1已被正式批准用于更换气缸盖中的金属,从而将制造商的重量减少...
新设计:透明可印刷塑料具有高导电性
- 阅156
扫描上图二维码,可以免费下载 搜料 APP 近日,美国机械工程研究科学家詹姆斯庞德和佐治亚理工学院的研究人员设计出一种透明聚合物薄膜。这种薄膜可以像其他常用材料一样有效地...
新机器人!采用聚氨酯弹性体的软体机器人可以实现自我修复
- 阅208
扫描上图二维码,可以免费下载 搜料 APP 如果机器人想要冒险进入人类无法到达的偏远环境,例如深海水下环境或偏远的外太空,他们不仅需要动力和到达那里的方式,还需要能够照顾...
1.凡本网注明“来源:搜料网”的所有文字、图片和音视频稿件,版权均为“搜料网”独家所有。转载请注明出处,并添加源链接,违反者本网将依法追究责任。
2.本网转载并注明其他来源的稿件或未注明“来源:搜料网”的所有文字、图片和音视频稿件,默认来源于网络,搜料发布目的在于传播更多信息,与本网站立场无关,如有侵权请直接与作者联系,或致电400-6700-720。
以上内容最终解释权归搜料网所有。